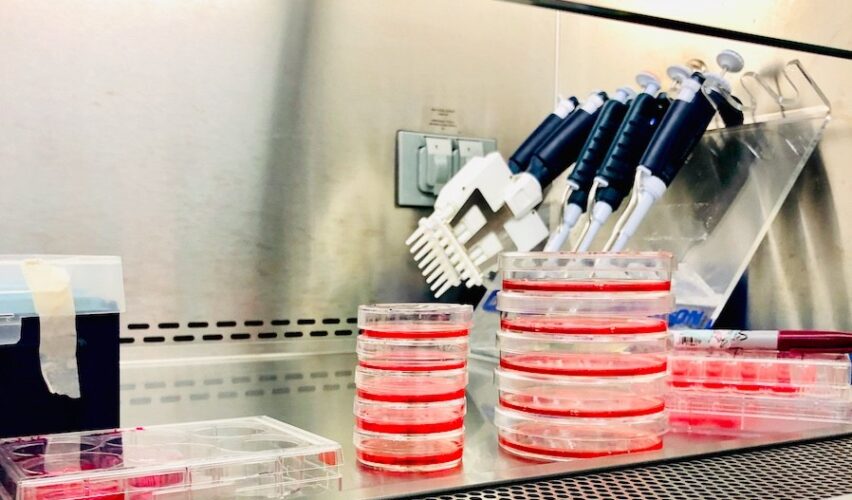

Los nanomateriales han irrumpido en nuestro mundo de manera silenciosa, pero revolucionaria, transformando la industria y desafiando nuestra comprensión de la materia. Estos diminutos componentes se caracterizan por tener al menos una de sus dimensiones entre 1 y 100 nanómetros. Los nanomateriales, llamados así por su tamaño tan pequeño, han abierto la puerta a nuevas aplicaciones y posibilidades que van más allá de lo que la vista humana puede percibir.
En este artículo, exploraremos qué son los nanomateriales, cómo se originan, su papel en diversas industrias y por qué es importante entender su presencia en productos que utilizamos diariamente.
El tamaño nano: más allá de lo visible
El prefijo “nano” quiere decir enano o pequeño. Para comprender el tamaño de los nanomateriales, podemos dividir imaginariamente en vertical un cabello humano en un millón de partes, una de ellas sería lo equivalente a un nanómetro. Es una escala en la que los átomos y las moléculas son los ladrillos fundamentales de la materia. El tamaño nanométrico confiere a los nanomateriales propiedades químicas y físicas únicas y sorprendentes, debido a que en esta escala las fuerzas y la química que gobiernan su comportamiento son diferentes a las que observamos en escalas macroscópicas.
Origen y clasificación de los nanomateriales
Los nanomateriales han existido desde siempre, pero sólo recientemente hemos desarrollado las herramientas para estudiarlos. Los nanomateriales se dividen en tres categorías, según su origen: biológicos, sintéticos e incidentales.
Los nanomateriales biológicos son entidades naturales, como los virus y las nanopartículas producidas por procesos como erupciones volcánicas. Por otro lado, la nanotecnología nos permite diseñar nanomateriales sintéticos en el laboratorio, que han encontrado aplicaciones en diversas industrias. Por último, los nanomateriales incidentales se generan como subproductos no intencionados de actividades humanas, como la quema de combustibles fósiles y la degradación de plásticos, representando preocupaciones para la salud y el medio ambiente.
Los nanomateriales en la industria
La presencia de nanomateriales en las industrias es innegable y transformadora. En la electrónica, la automotriz y la construcción, se aprovechan las propiedades de los nanomateriales para mejorar la eficiencia y las características de los productos. Sin embargo, su entrada en la industria alimentaria y cosmética puede generar preguntas y preocupaciones a largo plazo.
En la industria alimentaria, los nanomateriales sintéticos y naturales se utilizan para prolongar la vida útil de los alimentos y mejorar su calidad. Están presentes en bebidas, alimentos en polvo y ¡hasta en la sal! Su potencial impacto en la salud es motivo de investigación y debate, y la regulación en torno a su uso es un tema clave para ser tratado por parte de los gobiernos.
En la industria cosmética, los nanomateriales juegan un papel crucial: presentes en protectores solares que bloquean los rayos UV, hasta en labiales para mejorar los colores y en cremas antienvejecimiento, los nanomateriales han elevado la industria a nuevas alturas. Sin embargo, esto también plantea preguntas sobre la seguridad y la transparencia en el etiquetado de los productos comerciales que pudieran contener nanotecnología.
Nanomateriales y su regulación: el desafío
A medida que los nanomateriales se infiltran en nuestra vida diaria, la regulación se convierte en un desafío apremiante. La falta de divulgación de su uso y etiquetado dificulta que los consumidores tomen decisiones informadas. En este sentido, México ha dado pasos hacia la regulación de nanomateriales a través de instaurar Normas Mexicanas (NMX); sin embargo, estas siguen siendo voluntarias y su cumplimiento puede ser limitado.
Nanotoxicología: descifrando los efectos en la salud
El campo de la nanotoxicología busca entender cómo los nanomateriales afectan a los seres vivos y al medio ambiente. Con el rápido aumento de la producción y el uso de los nanomateriales, es esencial evaluar su seguridad, ya que pueden tener efectos tanto positivos como negativos en los organismos, y la nanotoxicología juega un papel vital en la evaluación de riesgos y en la garantía de un uso seguro y sostenible.
El futuro de los nanomateriales
A medida que continuamos integrando los nanomateriales a nuestra vida diaria, es fundamental abordar cuestiones de seguridad, regulación y ética. Los avances en la nanotecnología han llevado a logros notables en la medicina, la electrónica y más allá, pero también exigen una vigilancia constante para garantizar que los beneficios superen los riesgos. La investigación en nanotoxicología y la regulación efectiva serán pilares cruciales para asegurar que los nanomateriales sigan siendo una herramienta valiosa en la construcción de nuestro futuro.
Muchos se preguntarán, ¿quiénes trabajan con nanomateriales? Pues bien, en el Centro de Física Aplicada y Tecnología Avanzada de la UNAM (CFATA), en el Campus Juriquilla, Querétaro, trabajamos con la síntesis de nuevos y mejores nanomateriales, estudiamos sus propiedades físicas, químicas y biológicas; también estudiamos cuáles son los efectos a corto, mediano y largo plazo en diferentes tipos de células, para diversas aplicaciones que impulsarán la nanotecnología y favorecerán la resolución de problemas nacionales y de incidencia social.
Te invitamos a que visites el CFATA y revises su contenido digital en www.fata.unam.mx. Si quieres saber más de nanotoxicología, te invitamos a que sigas las redes sociales del Nanotox Lab por Facebook, Instagram y Tik Tok.

La doctora Karla Oyuky Juárez Moreno es investigadora asociada del Departamento de Nanotecnología en el Centro de Física Aplicada y Tecnología Avanzada de la UNAM Campus Juriquilla
kjuarez@fata.unam.mx
AQUI PUEDES LEER TODAS LAS ENTREGAS DE “DESDE LA UNAM”, LA COLUMNA DE LA UNAM, CAMPUS JURIQUILLA, PARA LALUPA.MX
https://lalupa.mx/category/aula-magna/desde-la-unam/